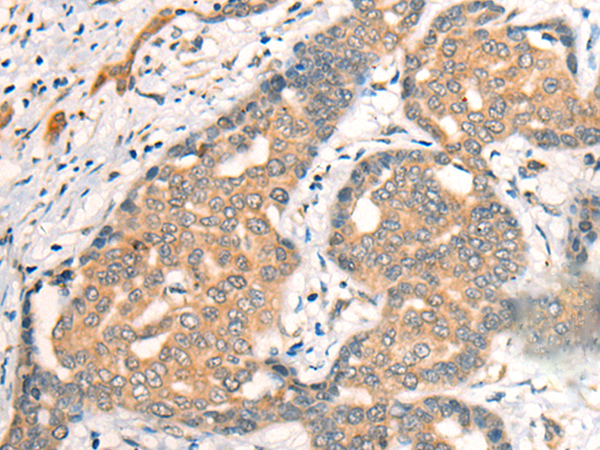
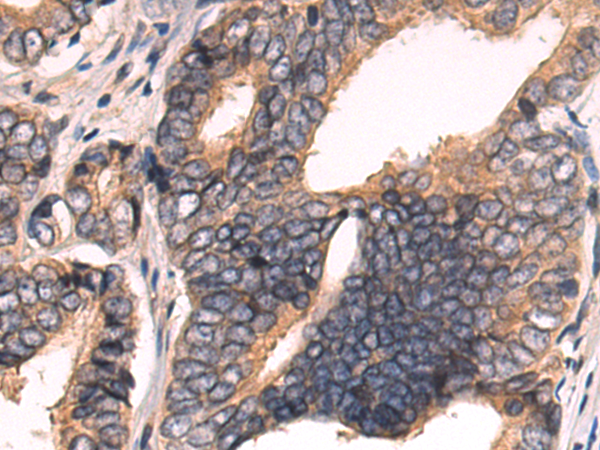
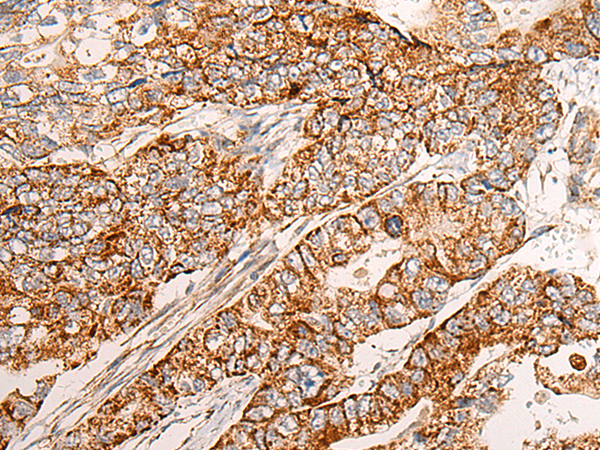

-
分类: 科研抗体货号: P09485别名: MVA2; PIG8; TSP57应用: WB,IHC反应种属: Human, Mouse, Rat
-
分类: 科研抗体货号: P09484别名: CT87; MKS4; POC3; rd16; BBS14; JBTS5; LCA10; NPHP6; SLSN6; 3H11Ag应用: IHC反应种属: Human, Mouse
-
分类: 科研抗体货号: P09501别名: XRN; CLC5; XLRH; CLCK2; ClC-5; DENTS; NPHL1; NPHL2; hCIC-K2应用: IHC反应种属: Human, Mouse, Rat
-
分类: 科研抗体货号: P09483别名: BITE应用: IHC反应种属: Human
-
分类: 科研抗体货号: P09517别名: MAST1应用: WB,IHC反应种属: Human, Mouse
-
分类: 科研抗体货号: P09500别名: CHI3; CHIT; CHITD应用: WB,IHC反应种属: Human
-
分类: 科研抗体货号: P09511别名: CIRP应用: IHC反应种属: Human, Mouse, Rat
-
分类: 科研抗体货号: P09516别名: CK2A2; CSNK2A1; CK2alpha'应用: WB,IHC反应种属: Human, Mouse
-
分类: 科研抗体货号: P09499别名: CHIT2; AMCASE; TSA1902应用: WB,IHC反应种属: Human, Mouse
-
分类: 科研抗体货号: P09510别名:应用: IHC反应种属: Human

鄂公网安备42018502007531号
鄂公网安备42018502007531号

